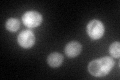
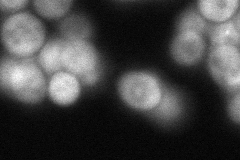
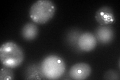
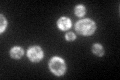

View description
Glycogen synthase, similar to Gsy1p; expression induced by glucose limitation, nitrogen starvation, heat shock, and stationary phase; activity regulated by cAMP-dependent, Snf1p and Pho85p kinases as well as by the Gac1p-Glc7p phosphatase
Localization:
Intensity:
Fold change:
Significance:
-
C’ GFP library in SD
cytosol71.18 -
N' NOP1pr-GFP in SD

cytosol,punctate130.825 -
N' TEF2pr-mCherry in SD

cytosol,punctate79.6381 -
N' NATIVEpr-GFP in SD
cytosol64.7736 -
N' TEF2pr-VC and Cyto-VN in SD

cytosol,punctate68.4935 -
C’ GFP library in SD+DTT
punctateN/AN/ANo -
C’ GFP library in SD+H2O2

cytosol94.941.33No -
C’ GFP library in Starvation Media
cytosol115.051.61Yes -
C’ GFP library on the background of Pup2-DaMP

cytosol -
C’ GFP library on the background of CCT mutant

cytosol66.92080.940055No
